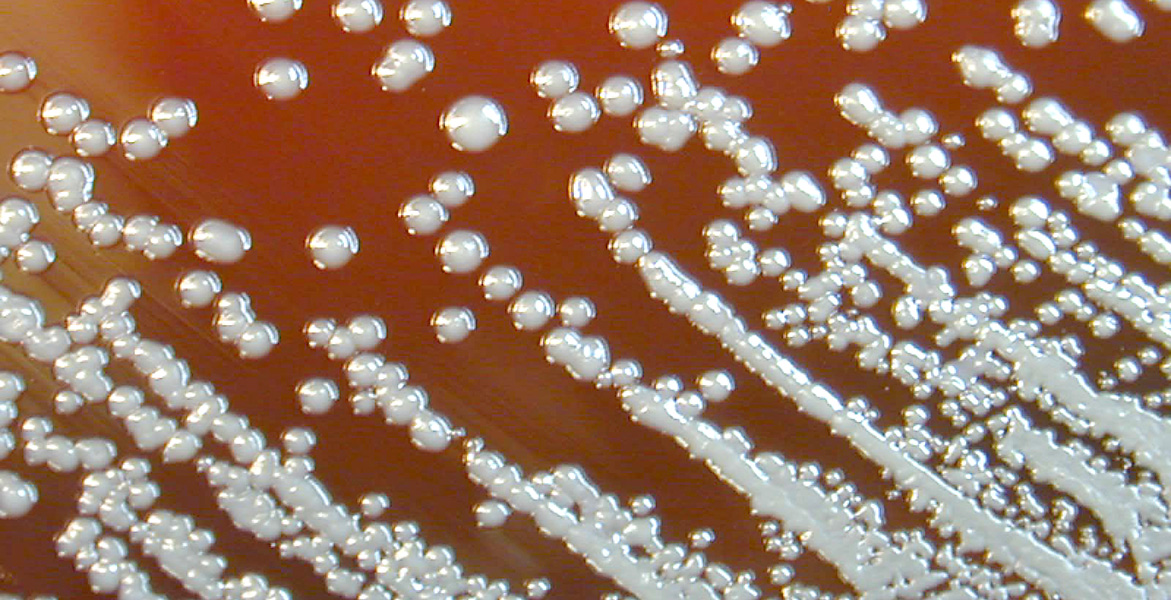

The edit
Conservantes en cosmética
Si hay algo positivo de la pandemia mundial que estamos viviendo es que nos ha hecho a todos conscientes de que los microorganismos están en todas partes, en el medio ambiente, en nuestra piel, en nuestra ropa, etc. Es por eso que creo que es un buen momento para hablar sobre los conservantes en cosmética y el por qué son necesarios.
El agua presente en limpiadores, tónicos, sérums y emulsiones, es el hábitat preferido para los microorganismos. Estos se caracterizan por tener la capacidad de multiplicarse y crecer muy rápidamente. Los productos de belleza son el caldo de cultivo perfecto para ellos.
La primera pregunta que suele surgir cuando hablamos sobre el tema de los conservantes en cosmética es, ¿por qué es importante tener un producto microbiológicamente puro? Un producto “contaminado” acarrea desde un olor desagradable, emisión de gases, color anormal, separación de fases del producto hasta disminuir su eficacia y en el peor de los casos la aparición de sustancias tóxicas que podrían causarnos daño. Los síntomas más comunes son erupciones, enrojecimiento, picazón en la piel y pústulas. Por lo tanto, son más críticos si estos ocurren en los ojos.
Por eso, aparte de que las marcas de cosmética trabajen en un ambiente aséptico y cumplan con las GMP (Buenas Normas de Fabricación), es necesario el uso de un conservante para evitar todo lo mencionado anteriormente. En otras palabras, es potencialmente más peligroso aplicar un producto sin conservantes que uno que contenga una mezcla eficaz a la dosis recomendada.
Así que hoy me gustaría compartir unas reglas básicas para que te conviertas en un profesional en la navegación por las inexploradas aguas de la conservación.
- Un producto “sin conservantes” puede contener conservantes como el ácido sórbico o el ácido benzoico, que son menos conocidos, pero aún así se clasifican como conservantes.
- Los conservantes tienen un riesgo mayor que otros ingredientes de desarrollar una reacción alérgica, pero algunos tienen un buen perfil de seguridad.
- Las dos categorías de productos con las que debemos tener más cuidado son todo lo que aplicamos alrededor del área de los ojos y en los niños.
- El propóleo y algunos aceites esenciales tienen propiedades antimicrobianas, pero, como formulador, necesito dosis muy elevadas para que funcionen, lo cual no es viable.
- A veces, la palabra “Parfum” en la etiqueta se refiere a una mezcla de aceites esenciales que tienen acción antiséptica y sus proveedores los venden como una alternativa a los conservantes tradicionales. Soy un poco escéptico acerca de ellos porque no tienen un amplio espectro, nuevamente las dosis deben ser más altas de lo habitual y si sufres de piel sensible te conviene evitarlos.
- Los productos muy ácidos o alcalinos son territorios muy hostiles para el crecimiento de bacterias, por lo que hay poca necesidad de conservación. Lamentablemente el pH del producto final es importante y la piel te lo agradecerá si aplicas productos con valores alrededor de 5 que es el pH de la piel.
- Una «gran» alternativa natural a los parabenos parece ser el extracto de semilla de pomelo, lástima que, a través de extensas pruebas, los científicos hayan encontrado triclosán y solventes sintéticos, así que permitidme reformularlo, este extracto natural no es una «gran alternativa natural”.
- El filtrado de fermento de raíz de rábano parece ser un conservante natural eficaz. Lo que no muestra la etiqueta es que contiene ácido salicílico, por lo que no es aconsejado utilizarlo durante el embarazo.
- A veces, bajo la afirmación de “sin parabenos”, encontramos otros conservantes como metilisotiazolinona y metilcloroisotiazolinona que se han asociado con alergias de contacto.
- 10. Como nota final, si necesitas mas información, búscala en fuentes oficiales como cir-safety.org